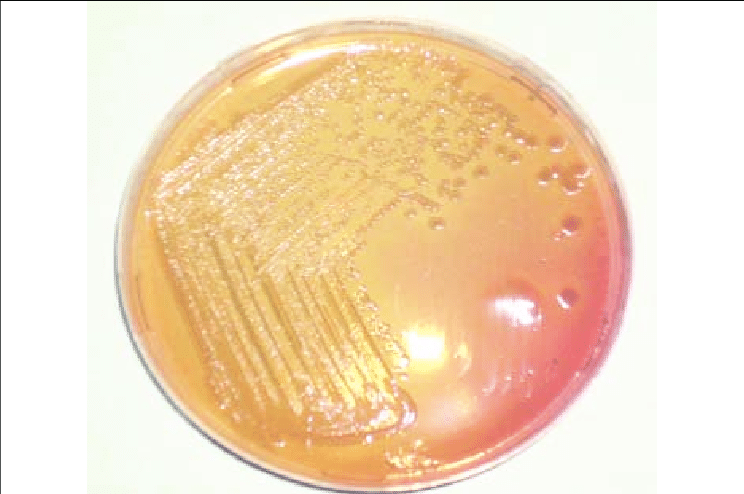

Why don't you make any transfers over your books and paper?
You may inadvertently contaminate them
What is a medium that contains living microbes?
A culture
What do you need to do if you don't understand the instructions?
Ask the professor I am assuming
What do you use to obtain separated microcolonies?
Streak plate method

What can you see?
Gram-positive S.aureus
What kind of method is better when you have diluted samples?
Serial dilution method
What are the hanging drop steps in order?
-Place a small drop of bacterial culture on a coverslip,
-Seal the coverslip with petroleum jelly around the edge of a concave slide
-Then invert the slide with the droplet hanging in the depression, and observe under a microscope
How should you not handle glassware?
Carry glassware by its neck or side, use one hand to carry glassware, stand or walk on broken glass, put broken glass into a regular waste basket, etc.
In what type of bacteria can catalase be found?
Aerobic bacteria
What are the chemicals that develop color as they oxidize?
Tetramethyl-p-phenylenediamine (TMPD)
What kind of experiments can you do in the laboratory?
this is self explanatory

What can you see?
Gram-positive spirillum
What enzyme transforms hydrogen peroxide into water and gaseous oxygen?
Catalase
What kind of method uses 3 streaks?
T-streak method
What is tolerated in the laboratory?
Self explanatory

what can you see?
Gram-negative cocci
What is it called when you have a culture with two or more species?
Mixed culture
Which characteristic indicates that you prepare all the materials you need before starting the experiment and put it following the exercise procedure steps?
Being prepared?
What is a substance designed to reduce the number of pathogens on a surface or in liquids?
Chemical germicides

What is this? (in OF)
control

What is this? (in OF)
Fermentation, E.coli

What is this? (in OF)
control
In what type of bacteria can't catalase be found?
Obligate anaerobic bacteria

What method is this?
Zig-zag streak
In the oxidase reaction, what is the enzyme that changes the color?
Cytochrome oxidase
What is a substance designed to reduce the number of pathogens in living tissue?
Antiseptics

What method is this?
Quadrant streak
If you carry a microscope, what should you not do?
Do not grasp it by the stage, eyepieces, objective lenses, or other small parts.
Always hold it by the arm and base with both hands for proper support.
What kind of method uses 4 streaks?
Quadrant streak
What is this? (in MacConkey)
Non-lactose fermenting colonies
What is the shape of your stain sample?
How to do a simple stain:
1. Sterilize inoculating loop
2. Obtain your sample and spread it on the slide
3. Allow the sample to air dry for 1 min
4. Fix the sample to the slide (pass over the flame)
5. Flood sample with simple stain (crystal violet, safranin, methylene blue)
6. Let the stain sit for 1 min
7. Rinse with DDH2O
8. Place the coverslip onto the slide
9. Look under the microscope

What can you see?
Gram-negative rods
What word do we use for something without contamination?
Uncontaminated
What is a substance designed to reduce the number of pathogens on a surface?
Disinfectants

What can you see?
Gram-positive rods
What can you do in the laboratory?
Self-explanatory